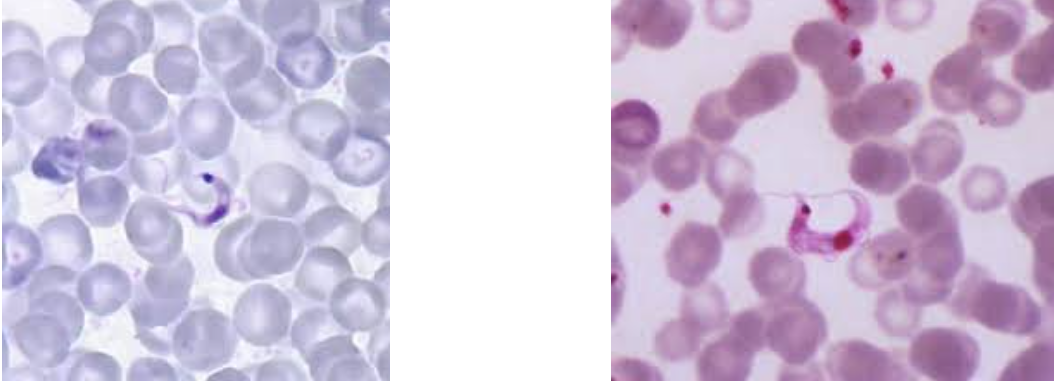
<p><span style="background-color: rgba(0, 0, 0, 0); line-height: 19.7625px;">What is the species in this photo and WHY?</span></p>
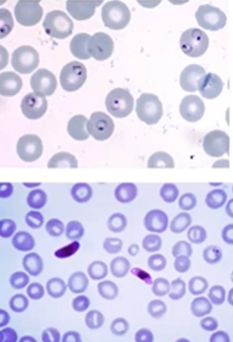
<p><span style="background-color: rgba(0, 0, 0, 0); line-height: 19.7625px;">What is the species in this photo and WHY?</span></p>
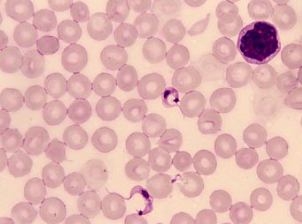
<p><span style="background-color: rgba(0, 0, 0, 0); line-height: 19.7625px;">What is the species in this photo? what disease is it associated with?</span></p>
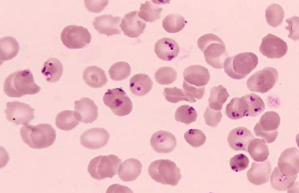
<p>What disease is this patient infected with?</p>

Microbiology Unit 4 Photographs
1/98
There's no tags or description
Looks like no tags are added yet.
Name | Mastery | Learn | Test | Matching | Spaced | Call with Kai |
|---|
No analytics yet
Send a link to your students to track their progress
99 Terms

What is the species seen in this photo and WHY?
Entamoeba histolytica troph. RBCs present, bullseye nucleus (cysts CANNOT eat RBCs)

What is the species seen in this photo and WHY?
Entamoeba histolytica troph. RBCs present (cysts CANNOT eat RBCs)

What is the species seen in this photo and WHY?
Entamoeba histolytica troph. RBCs present, bullseye nuscleus (cysts CANNOT eat RBCs)

What is the species seen in this photo and WHY?
Entamoeba histolytica troph. RBCs present, bullseye nuscleus (cysts CANNOT eat RBCs)

What is the species seen in this photo and WHY?
Entamoeba histolytica/ Dispar. No RBCs seen (unable to differentiate due to this)

What is the species seen in this photo and WHY?
Entamoeba histolytica/ Dispar. No RBCs seen (unable to differentiate due to this)

What is the species seen in this photo and WHY?
Entamoeba histolytica/Dispar CYST. Cysts to not eat RBCs and it is very rounded with multiple nuclei. (cannot differentiate bc no RBCs)

What is the species seen in this photo and WHY?
Entamoeba histolytica/Dispar CYST the dark line is a chomatoidal bar

What is the species in this photo and WHY?
Entamoeba histolytica/Dispar CYST. Cysts to not eat RBCs and it is very rounded with 4 nuclei

What is the species in this photo and WHY?
Entamoeba hartmanni troph, the size (troph because it is not perfectly round)

What is the species in this photo and WHY?
Entamoeba hartmanni cyst. The size, it is perfectly round and the dark purple bars are seen

What is the species in this photo and WHY?
Entamoeba hartmanni troph, note the size, not perfectly round.

What is the species in this photo and WHY?
Entamoeba coli troph. Not perfect circle, blotchy chromatin, off center karyosome (spot inside the nucleus)

What is the species in this photo and WHY?
Entamoeba coli troph Not perfect circle, blotchy chromatin, off center karyosome (spot in nucleus)

What is the species in this photo and WHY?
Entamoeba coli troph Not perfect circle, blotchy chromatin, off center karyosome (spot in nucleus)

What is the species in this photo and WHY?
Entamoeba coli troph Not perfect circle, blotchy chromatin, off center karyosome (spot in nucleus)

What is the species in this photo and WHY?
Entamoeba coli cyst. Perfectly round and has 5 nuclei

What is the species in this photo and WHY?
Entamoeba coli cyst. Perfectly round and has 5 nuclei (trophs only have one nuclei)

What is the species in this photo and WHY (size 20 μm)?
Entamoeba coli cyst. Size, 4 nuclei, uneven chromatin, non centric karyosome (the line INSIDE the nuclei)

What is the species in this photo and WHY?
Entamoeba coli cyst. Size,has 5-6 nuclei (its shape is irregular but only cysts have that many nuclei)

What is the species in this photo and WHY?
Endolimax nana troph, irregular shape, small, non bullseye nucleus (lil dot)

What is the species in this photo and WHY?
Endolimax nana troph, irregular shape, small, non bullseye nucleus (lil dot)

What is the species in this photo and WHY?
Endolimax nana troph, irregular shape, small, non bullseye nucleus (lil dot)

What is the species in this photo and WHY?
Endolimax nana troph, irregular shape, non bullseye nucleus (lil dot) (NOTE: in very clear zoomed in pics, a clear line around the nucleus can be seen in nana)

Which TWO parasites are seen here and how did you differentiate them?
Endolimax nana on the left, BLOB nucleus, entamoeba hartmanni on the right BULLSEYE nucleus (lil dot)

What is the species in this photo and WHY?
Endolimax nana cyst, rounded with 4 “button hole” nuclei (lil dots)

What is the species in this photo and WHY?
Endolimax nana cyst, rounded with 4 “button hole” nuclei (lil dots) SMALL SIZE

What is the species in this photo and WHY?
Iodamoeba butschlii cyst, LARGE karyosome (nucleus), blob like “empty looking” nucleus

What is the species in this photo and WHY?
Iodamoeba butschlii cyst, LARGE karyosome (nucleus), blob like “empty looking” nucleus

What is the species in this photo and WHY?
Iodamoeba butschlii cyst, LARGE karyosome ( spot in nucleus), blob like “empty looking” nucleus

What is the species in this photo and WHY?
Iodamoeba butschlii troph, blob like nucleus, granular cytoplasm

What is the species in this photo and WHY?
Giardia Duodenalis troph, kite shape with eye nuclei and mouth

What is the species in this photo and WHY?
Giardia Duodenalis cyst. Cysts are oval shaped, can have up to 4 nuclei (looks like “junk” in the middle)

What is the species in this photo and WHY?
Giardia Duodenalis cyst. Cysts are oval shaped, can have up to 4 nuclei (looks like “junk” in the middle)

What is the species in this photo and WHY?
Dietamoeba fragilis troph, binucleiate, delicate nuclear membrane

What is the species in this photo and WHY?
Trichomonas vaginalis, ONE nuclei, 4 anterior flagella extending one half length of the body

What is the species in this photo and WHY?
Leismania

What is the species in this photo and WHY?
Trypanosomas brucei gambiense

What is the species in this photo and WHY?
Cryptosporidium (stained red from modified acid fast)

What is the species in this photo and WHY? Where is it found?
Schistosoma mansoni (has a VISIBLE lateral spine the pokey part) Stool

What is the species in this photo and WHY? Where is it found?
Schistosoma haematobium (has a visible terminal spine) Urine

What is the species in this photo and WHY? Where is it found?
Schistosoma japonicum (no spine oval/round) Stool

What is the species in this photo and WHY?
Enterobius vermicularis (pinworm)

What is the species in this photo and WHY?
Enterobius vermicularis (pinworm)

What is the species in this photo and WHY?
Ascaris lumbricoides (intestinal roundworm)

What is the species in this photo and WHY?
Ascaris lumbricoides (intestinal roundworm) fertilized egg

What is the species in this photo and WHY?
Ascaris lumbricoides (intestinal roundworm) unfertilized egg

What is the species in this photo and WHY?
Trichuris trichura (whipworm)

What is the species in this photo and WHY?
Hookworm egg

What is the species in this photo and WHY?
Hookworm

What is the species in this photo and WHY?
Strongyloides stercoralis

What is the species in this photo and WHY?
Diphyllobothrium latum

What is the species in this photo and WHY?
Taenia saginata and solium
What is the species in this photo and WHY?
Trypanosome cruzi

What is the species in this photo and WHY?
Plasmodium vivax
What is the species in this photo and WHY?
Plasmodium falciparum (banana shape)

What is the species in this photo and WHY?
Plasmodium malariae (permanently banned from donating blood)

What form of plasmodium is this?
Ring-form

What form of plasmodium is this?
Trophozoite

What form of plasmodium is this?
immature schizont

What form of plasmodium is this?
Mature schizont

What form of plasmodium is this?
Gametocytes

What is the species in this photo? What type of egg? How do you get infected with it?
Schistosoma mansoni egg, fluke, skin penetration

What is the species in this photo? What type of egg? How do you get infected with it? Common name?
Diphyllobothrium latum egg, tapeworm egg, eating raw fish, fish tape

What is the species in this photo? WHY?
Giardia troph (junk in the middle)

What is the species in this photo? how do you get infected with it?
Hookworm, through the skin

What is the species in this photo? why?
Iodameoba butschlii (empty spot in the middle)

What is the species in this photo? Is this stage the infective stage?
Fertilized ascaris, yes

What is the species in this photo?
Tapeworm

What is the species in this photo? what is its common name? how do you get infected?
Trichuris trichuria egg, whipworm, ingesting the egg

What is the species in this photo?
Pinworm (scotch tape prep)

What is the species in this photo?
Roundworm

What is the species in this photo?
Giardia troph

What is the species in this photo? It is from a fresh stool.
Rhabditiform larvae Stronyloides

What is the species in this photo?
Pinworm (enterobius vermicularis)
What is the species in this photo? what disease is it associated with?
Trypanasoma cruzi, chagas

What is the species in this photo? Where is this?
Trichinella, muscle biopsy

What is the species in this photo?
Trichomonas

What is the species in this photo? Is this the infective stage? How do you get infected with this?
Fertilized ascaris egg, yes, ingesting egg

What is the species in this photo?
Trichuria Trichiura egg
What disease is this patient infected with?
Malaria

What is the species in this photo?
Strongyloides rhabidiform larvae

What is the species in this photo?
Taenia egg

What is the species in this photo? WHY?
Taenia solium (double row of 25-30 hooklets and 4 suckers)

What is the species in this photo? How is it acquired? is this the infective stage? What specimen would be submitted to the lab to look for this species?
Hookworm egg, through the skin, no, stool

What is the species in this photo?
Histo cysts

What is the species in this photo?
Diphyllobothrium latum egg

What is the species in this photo?
Schistosoma mansoni egg

What is the species in this photo?
Schistosoma haematobium egg

What is the species in this photo? why?
Dientamoeba fragilis (two eyes)

What is the species in this photo?
Trichomonas

What is the species in this photo?
Trypanosomes

What is the species in this photo?
Endolimax nana

What is the species in this photo?
Dientamoeba fragilis

What is the species in this photo?
E. Histolytica cysts

What is the species in this photo? WHY?
Cryptosporidium (modified acid fast-red)

What is the species in this photo?
ARTIFACT- pollen

What is the species in this photo?
ARTIFACT- pollen

What is the species in this photo?
ARTIFACT- yeast